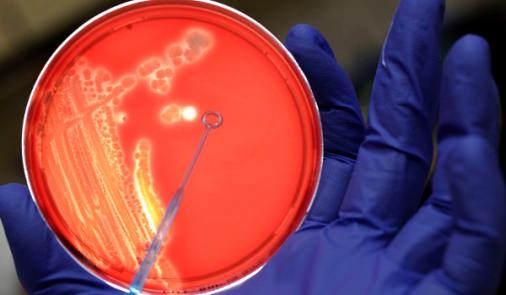

gripalizar
Tanto el verbo gripalizar como su derivado gripalización están adecuadamente formados.

La grafía recomendada para el nombre abreviado del ‘síndrome respiratorio agudo producido por un coronavirus’ es el/la COVID-19, con mayúsculas, que proviene de la sigla inglesa de coronavirus disease, ‘enfermedad del coronavirus’. Leer más

Las claves de vacuna, que hicieron de esta voz la palabra del año de la FundéuRAE.
Leer más
En este artículo de nuestro blog damos una lista de los nombres en español de las letras griegas, que sirven para dar nombre a las variantes: delta, ómicron...
Leer másPuedes consultar una selección de nuestros consejos lingüísticos sobre este tema en la recomendación general sobre claves del coronavirus.
Además, puedes navegar por todo el contenido relacionado que está recogido a continuación.

Tanto el verbo gripalizar como su derivado gripalización están adecuadamente formados.

La voz flurona, de nueva formación, alude a la infección simultánea de gripe y covid-19.

El nombre de la nueva variante del SARS-CoV-2 detectada en Sudáfrica es ómicron, con tilde en la primera o y en minúscula.

Las palabras sobreaforo y sobrecupo, así como la expresión exceso del aforo, y no exceso de aforo, son adecuadas para indicar que la capacidad máxima de un recinto se ha sobrepasado.

El nombre de una proteína del virus SARS-CoV-2 que en inglés se conoce como spike protein es proteína de la espícula, no proteína spike.

El uso de la sigla inglesa CAR-T (o CAR T), que hace referencia a los linfocitos o células T con receptores quiméricos para antígenos, está asentado en español y no resulta censurable.

Cuando combatir significa ‘hacer frente a algo que se considera perjudicial para detenerlo o destruirlo’, no va seguido por la preposición contra.

Las expresiones vacuna/dosis de refuerzo o de recuerdo son algunas de las alternativas que se pueden usar en español en lugar del anglicismo booster en el ámbito de la medicina..

Viral y vírico pueden utilizarse indistintamente, en el ámbito de la medicina, ya que se consideran sinónimos.

Las variantes del SARS-CoV-2 que se conocen como delta y delta plus se escriben con minúsculas.

La expresión certificado COVID (o covid) digital se escribe con las palabras certificado y digital en minúsculas.
Patología significa ‘parte de la medicina que estudia las enfermedades’ y ‘conjunto de síntomas de una enfermedad’, de acuerdo con la Academia, de modo que solo puede considerarse sinónimo de enfermedad en un uso no especializado.

Se recomienda evitar el uso de suero para aludir a
una vacuna, dado que es un tipo de medicamento distinto.

Los términos que se emplean para indicar los diferentes
tipos de mascarillas, cubrebocas, nasobucos, barbijos o
tapabocas, según el país, se escriben generalmente con
minúsculas (higiénicas, quirúrgicas), no los formados por una sigla (FFP1, FFP2, N95, KN95).

Los nombres de síndromes, como el síndrome de la
cabaña o el síndrome de la cara vacía, entre otros, se escriben con minúsculas y sin comillas.

El sustantivo español condición no es adecuado con
el sentido de la voz inglesa condition de ‘enfermedad’ o ‘afección’.

Puntos de vacunación masiva, con el adjetivo en
femenino y singular, y no puntos de vacunación
masivos, es la forma adecuada de referirse a estos lugares de administración de vacunas contra la covid-19.

Operativo Correcaminos y brigada Correcaminos son las formas apropiadas de escritura para las correspondientes etiquetas del plan de vacunación del Gobierno mexicano.

La expresión (persona) con COVID-19 persistente, no (persona) COVID-19 persistente, es la adecuada para sustituir el anglicismo long hauler.

En textos médicos, las voces coágulo y trombo, que de forma general aluden a la ‘masa semisólida formada por la coagulación de un líquido, como sangre’, tienen distintos matices que conviene tener en cuenta.

Inyectar alude a una de las formas en que se administra una vacuna, pues no todas ellas se inyectan (las hay orales e intranasales).

El sustantivo tripanofobia es adecuado para hacer referencia al miedo irracional a las inyecciones.

Vacunar es un verbo transitivo, la persona que recibe la vacuna es el complemento directo, por lo que lo adecuado es emplear los pronombres lo y la, aunque usar el pronombre le, cuando el referente es masculino singular, no se considera incorrecto.

Zoonosis, palabra que se emplea para referirse a las enfermedades de los animales que pueden transmitirse a las personas, se escribe sin tilde.

Los nombres comerciales de las vacunas y de las empresas farmacéuticas, al ser nombres propios, se escriben con mayúsculas iniciales.

Lo adecuado es los CDC, no el CDC, para hacer referencia a los Centros para el Control y Prevención de Enfermedades.

Se escribe monodosis y unidosis, sin espacio.

La voz vacunódromo, con la que se alude, generalmente, a grandes instalaciones habilitadas para vacunar, es válida en español.

En el nombre de la vacuna rusa Sputnik V, la letra final no representa un número romano, sino la uve o ve baja.

Lo adecuado es escribir unidades de cuidados respiratorios intermedios, con minúsculas, y su sigla es UCRI, que lexicalizada es ucri.

El término antídoto es el adecuado para referirse al ‘medicamento que se emplea contra un veneno’ o la ‘medicina o sustancia que contrarresta los efectos nocivos de otra’, por lo que no es apropiado emplear esta voz como sinónimo de vacuna.

Nelly y Erik, que es como se están denominando dos mutaciones del virus causante de la covid-19, se escriben con mayúscula inicial y no necesitan comillas ni cursiva.

Reescalada, escrito preferiblemente con dos es, es un término adecuado para referirse a la situación en la que vuelve a aumentar algo, sobre todo cuando es rápido, como está sucediendo con los nuevos brotes de COVID-19.

El líquido o gel que se usa a menudo como desinfectante de manos se llama hidroalcohólico, y no son adecuadas las grafías hidro alcohólico o hidro-alcohólico, con espacio o guion, ni hidroalcólico, sin la hache intercalada.

Las palabras brote y rebrote, por un lado, y ola y oleada, por otro, se emplean a menudo de forma indistinta, pero encierran matices que conviene tener en cuenta para una redacción más exacta.

La palabra preliminar, aplicada a lo que sirve de introducción a algo, se escribe con una sola e, no preeliminar.

La expresión confinamiento selectivo es preferible a confinamiento quirúrgico para referirse a la reclusión de personas concretas recientemente contagiadas por el coronavirus o que se hallan o han estado en contacto con estas.

Eliminar es el verbo más adecuado para expresar que una enfermedad deja de estar presente en un determinado país o territorio, mientras que erradicar una enfermedad supone, en la jerga técnica, eliminarla por completo.

Decaer incluye la acepción ‘quedar sin efecto’ como propia del ámbito jurídico, por lo que su uso referido al estado de alarma es apropiado.

Las expresiones dar de alta y dar el alta comparten significado en el contexto médico, pero se construyen con diferentes pronombres: lo(s) y la(s) en el primer caso (lo/la/los/las dieron de alta) y le(s) en el segundo (le/les dieron el alta).

Es una palabra propia del ámbito médico que, como explica el Diccionario de términos médicos de la Real Academia Nacional de Medicina, designa a...

Una de las creaciones léxicas que han surgido es este término con el que se alude a la tristeza de permanecer encerrados en casa...

El giro cita previa tiene uso desde hace, como poco, un siglo y está asentado para aludir a aquella solicitud de cita que sigue unas determinadas formalidades...

Abrir y reabrir, mejor que aperturar y reaperturar, son los verbos relacionados con los sustantivos apertura y reapertura.

Aunque en el lenguaje general se considera válido emplear ambos sustantivos como sinónimos, en el lenguaje médico y entre los especialistas...

Lo adecuado es fase uno, en masculino porque concuerda...

Tanto COVID-19, con la sigla enteramente en mayúsculas, como covid-19, como sustantivo lexicalizado en minúsculas, son grafías adecuadas para referirse a la enfermedad del coronavirus, pero no resulta apropiada la forma Covid-19, únicamente con la c inicial en mayúscula.

En español, gestos barrera es una expresión que se emplea en el ámbito de la sociología y la psicología, como parte de la comunicación no verbal, para referirse a...

¿Es correcto usar la expresión muertes per cápita en lugar de tasa de mortalidad?

Aforo es el número máximo autorizado de personas que puede admitir un recinto, no el número o cantidad de asistentes a un acto.

La expresión distanciamiento físico hace referencia a la mayor o menor lejanía entre las personas, que puede medirse en metros, mientras que distanciamiento social alude al grado de aislamiento de una persona o un colectivo en el seno de su sociedad.

Conviviente figura en algunos diccionarios de uso, como el Clave, y es una voz que no cabe censurar: está bien formada a partir de...

La grafía «resiliencia», con «i» después de la «l», y no «resilencia», es la adecuada para referirse a la capacidad de adaptación y recuperación frente a una situación adversa.

Esta secuencia de palabras, en efecto, puede resultar paradójica...

Estos verbos tienen ligeros matices diferentes, aunque pueden aparecer en los mismos contextos...

Tanto poscoronavirus como pos-COVID-19 (o pos-COVID) son grafías adecuadas.

El término viricida es el adecuado para referirse a todo aquello que es capaz de acabar con un virus, por lo que se desaconseja la voz virucida.

En la expresión plasma de convaleciente, que refiere a ciertas sustancias extraídas de la sangre que pueden emplearse en algunos tratamientos médicos, no es adecuado omitir la preposición de.

La sigla inglesa PCR se desarrolla como polymerase chain reaction, que equivale en español a reacción en cadena de la polimerasa...

La expresión gran confinamiento se escribe con minúsculas cuando tiene valor meramente descriptivo, mientras que comienza con iniciales mayúsculas (Gran Confinamiento) si se emplea de manera antonomástica para referirse el periodo de crisis provocado por la pandemia de COVID-19.

El sustantivo chinocentrismo es preferible a sinocentrismo para referirse a la tendencia a considerar a China como el eje y centro de las políticas mundiales.

Es un sustantivo correctamente formado a partir del griego iatrós (‘médico’ ) y –fobia (‘aversión o rechazo’ ).

Existe gran vacilación en el uso de las mayúsculas y minúsculas en este caso...

Tanto diagnosticar una enfermedad a una persona, opción tradicionalmente recomendada, como ser (alguien) diagnosticado de una enfermedad, variante muy extendida, son expresiones adecuadas.

Los términos formados con el elemento sero-, que alude a los sueros, como seroprevalencia o serotipo, se escriben con ese inicial y sin espacio ni guion.

El verbo desconfinar está bien creado a partir de confinar. Igualmente válido es el sustantivo derivado desconfinamiento.

Los sustantivos escalada y desescalada son adecuados para referirse al aumento de algo, sobre todo cuando es rápido, y a su posterior disminución, aunque existen en el español otras alternativas como aumento/disminución, incremento/rebaja o intensificación/relajación.

El término geolocalización, con el que se alude a la acción de obtener la ubicación geográfica real de un objeto, como un teléfono móvil, gracias a los sistemas de posicionamiento, se escribe en una sola palabra, sin espacio ni guion intermedios.

Para describir la forma de un objeto, un lugar o una gráfica cuya apariencia se asemeja a la de una letra (por lo general, mayúscula) lo recomendable es escribir el nombre de esta («en forma de uve») o la propia letra con la forma que se busca representar («en forma de V»), sin necesidad de comillas ni cursiva.

Enfrentarse, con el significado de ‘hacer frente a alguien o algo, especialmente a un problema o peligro’, se emplea con las preposiciones a o con, por lo que se desaconseja la forma enfrentarse ante.

El sustantivo escenario, que, entre otras cosas, significa ‘posibilidades o perspectivas de un hecho o de una situación’, tiene sinónimos en español.

El término mutualizar, con el significado de ‘hacer que algo sea mutuo o recíproco’, está bien formado y su uso es válido.

Si se desea emplear esta expresión es conveniente escribirla con la palabra arca en minúscula...

El verbo desinfectar, no sanitizar, es el adecuado para referirse, en el ámbito de la sanidad, a la acción de ‘eliminar todos o casi todos los microbios patógenos, con excepción de las esporas bacterianas, de la superficie de un objeto o de un ser vivo mediante la aplicación de medios químicos o físicos’.

Choque, impresión, conmoción, sorpresa o impacto son alternativas en español a la voz inglesa shock.

Aunque en principio pueda dar esa impresión, no se trata de una formulación incorrecta...

Los nombres comerciales de los medicamentos se escriben con inicial mayúscula, pero los nombres de los principios con los que se producen se escriben en minúscula.

En las informaciones sobre la pandemia de la COVID-19 se mencionan a menudo las unidades de cuidados intensivos. En este enlace se ofrecen claves para redactar adecuadamente las noticias en las que aparecen este y otros términos relacionados.

Máximo, nivel más alto o pico (donde esta voz no sea malsonante) son alternativas en español al anglicismo peak.

Aunque no son términos sinónimos, el Diccionario define cuarentena como...

El término infección, y no infectación, es el adecuado para aludir a la invasión de un ser vivo por un microorganismo patógeno, como un virus o una bacteria.

La grafía dar abasto, en dos palabras, es la adecuada para indicar que alguien o algo es suficiente para llevar a cabo una tarea o cubrir una necesidad, por lo que se desaconseja escribir dar a basto.

La denominación estado de alarma, que alude a una situación en la que se otorgan al Gobierno poderes especiales, se escribe con iniciales minúsculas.
Leer más
El anglicismo lockdown, que alude a la reclusión forzosa de los habitantes en sus casas o en una zona determinada, tiene alternativa en español: confinamiento.

El término aplausazo, que se usa especialmente en países como Argentina, es adecuado para referirse a un aplauso multitudinario...

Las expresiones vacuna contra la COVID-19 y vacuna anti-COVID-19 son más precisas y resultan, por tanto, preferibles a vacuna contra el coronavirus...

La expresión paciente cero no es censurable en el español general, pero...

El término infodemia, que se emplea para referirse a la sobreabundancia de información (alguna rigurosa y otra falsa) sobre un tema, está bien formado y, por tanto, se considera válido.

Lo adecuado es que a la sigla EPI, que significa ‘equipo de protección individual’, no se le añada una s para formar el plural.

Cuidaos es la forma de imperativo. Cuidaros, la del infinitivo.

Acrónimo formado a partir de coronavirus y bono.

La expresión dar positivo en algo es la preferible para indicar que se ha detectado un organismo o una sustancia en un control, aunque también es adecuado dar positivo por algo.

Extubar es el término más utilizado en el ámbito médico.

Supercontagiador, supervector o superpropagador son alternativas preferibles en español al anglicismo super spreader.

El sustantivo triaje, que se emplea en medicina para referirse a la clasificación de los pacientes según un sistema de prioridades para que se les pueda proporcionar la asistencia médica necesaria, se escribe con jota, no triage.

Según el Diccionario de términos médicos de la Real Academia Nacional de Medicina, se pronuncia como voz esdrújula y es conveniente escribirlo en cursiva y sin tilde.

El sustantivo anticoronavirus se escribe en una sola palabra, sin guion ni espacio intermedios, mientras que anti-COVID-19 se escribe con guion después del prefijo anti-.

El sustantivo cortacircuitos es una alternativa a la expresión inglesa circuit breaker, empleada en noticias bursátiles sobre el cese automático de la negociación de valores.

Medicalizar es un verbo válido para indicar que algo se equipa con lo necesario para ofrecer asistencia médica.

Inmunidad del rebaño es la traducción literal de la expresión inglesa herd immunity...

A partir del sustantivo cuarentena es posible derivar el verbo cuarentenar, válido para referirse a la acción de ‘poner en cuarentena un lugar o a una persona’.

En la lengua escrita, a la sigla ERTE (‘expediente de regulación temporal de empleo’) no se le añade una s para formar el plural.

La Organización Mundial de la Salud emplea pandemic, no global pandemic, en su comunicado oficial en inglés sobre la COVID-19...

Los términos teletrabajo y teletrabajador se escriben en minúscula, en una sola palabra y sin guion.

Para indicar que se retrasa el momento de realizar algo hasta otra fecha, tanto aplazado a como aplazado hasta son construcciones válidas.

El término inglés online puede traducirse por en línea, por internet, en internet, digital, electrónico o conectado, según el contexto.

La expresión tasa de mortalidad, y no de mortandad, es la adecuada cuando se hace referencia a la tasa de muertes en un tiempo dado.

La Real Academia Nacional de Medicina (España), consultada por la Fundéu, señala que no se trata de un uso correcto y prefiere hablar de curados que vuelven a dar positivo.

Sangría, sangradura y parte, flexura o lado interno del codo son denominaciones válidas.

El anglicismo sell-off, que se utiliza para referirse a la venta multitudinaria de acciones en bolsa, puede traducirse al castellano como venta masiva u oleada de ventas.

Existencias, mercancías almacenadas, excedente o la adaptación estocaje son, en función del contexto, alternativas en español al anglicismo stock.

Una epidemia es una enfermedad que se propaga por un país durante algún tiempo, una pandemia se extiende a otros países, tal como señala el Diccionario de términos médicos, de la Real Academia de Medicina.

El término severo, en español, equivale a ‘riguroso, áspero, duro en el trato’ o ‘exacto y rígido’ y no tiene las acepciones de la voz inglesa severe.

Estas dos expresiones no significan lo mismo.

Con motivo de los casos confirmados de la enfermedad del coronavirus en Italia y del aislamiento impuesto en diversas zonas de este país, se ofrecen los nombres tradicionales en español de las principales ciudades y regiones italianas que se están viendo afectadas

El verbo repatriar se puede acentuar como anunciar o como enviar, por lo que resulta adecuado escribir tanto repatria como repatría.

El elemento sino- está vinculado al estudio de la lengua y la cultura de la China, mientras que chino- remite más a la mera pertenencia o conexión con el país.

Haciendo clic en el enlace puedes escuchar cómo se pronuncia el nombre de esta ciudad y de la provincia de la que es capital.